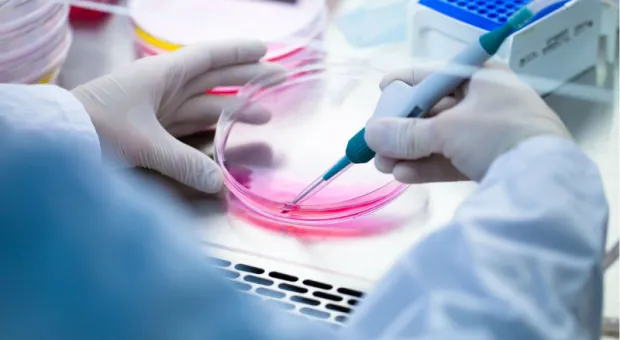
Мировые новости - Почему крымчанам не стоит бояться дефицита лекарств — мнение

В Крыму следователи заинтересовались отсутствием лекарств у больных детей
Маленькие пациенты годами недополучали положенную помощь.
18/08/2022 10:16
3
395
Россиянам в качестве эксперимента облегчат доступ к лекарствам
Пока в новом формате продажи лекарств будут участвовать три региона страны.
02/08/2022 10:27
1
665
В Крыму пытаются удержать цены на продукты и лекарства
В ближайшее время запланированы доставки самого необходимого.
16/03/2022 11:14
0
872
Севастопольцы активно раскупают лекарства в аптеках
Ажиотажный спрос фиксируется на препараты постоянного приема.
11/03/2022 17:00
10
3855
Почему крымчанам не стоит бояться дефицита лекарств — мнение
Возможные перебои с поставками вряд ли затянутся надолго, считают специалисты.
04/03/2022 19:13
4
1102
Открыто лекарство от старости, убирающее стареющие клетки
Японские ученые выяснили, как остановить старение и омолодить организм: они разработали препарат, который убираетиз организма старые клетки. По словам
19/02/2021 10:15
13
В Севастополе нет проблем с лекарствами от «сложных» болезней
Про цифры и деньги – главный врач инфекционной больницы Инга Матяж.
20/11/2019 15:02
2
874
Просроченными лекарствами в Севастополе занялись правоохранители
Пока ни одна упаковка не уничтожена, заверили в Севздраве.
23/10/2019 17:51
7
2253
Проблем с инсулином у льготников Севастополя нет и не будет, – горздрав
Все виды необходимого для пациентов препарата в городе присутствуют.
23/10/2019 17:02
8
818
Уничтоженные в Севастополе лекарства были закуплены с почти истекшим сроком годности
КСП утверждает: сложившаяся в городе система лекарственного обеспечения неэффективна.
16/10/2019 09:03
11
3051
Горздрав напомнил о правилах ввоза лекарств
Из-за рубежа можно ввозить лекарства только для личного пользования при наличии соответствующих документов.
24/08/2019 11:00
5
1497
Севздрав назвал стабильной ситуацию с льготными лекарствами
Есть только точечные проблемы с обеспечением.
19/08/2019 18:33
6
868
В Севастополе вновь начались перебои с выдачей льготных лекарств
В частности, речь идёт об обеспечении больных, страдающих сахарным диабетом.
18/08/2019 13:00
11
1817
В Севастополе выявили нарушения прав на льготные лекарства
В ведомстве не уточняют, в каком именно объёме были выявлены нарушения.
17/06/2019 13:35
2
1378
В Севастополе заканчивается вакцина против кори
Но в ближайшее время врачи ждут пополнения запасов.
06/02/2019 18:31
3
1598
Полцарства —— за лекарства!
28/01/2009 09:11
2270
О проверках цен на лекарственные препараты
22/01/2009 09:10
2271

.webp)
